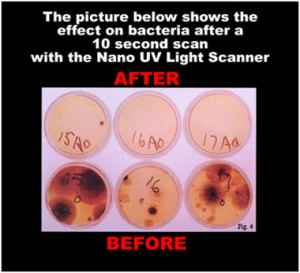
Proof Positive?

Let me say at the outset that I am not a fan of cell phones. In my view these anti-social devices have done more to damage quality of life (and, when in the hands of moronic drivers, to actually end life) than any other modern invention. It is no longer possible for me to enjoy a day at the beach, or a romantic dinner without being irritated by the constant ring tones and inane, high-decibel chatter of those around me, or, much worse, by my pointy-haired boss who is so dim he thinks an after hours computer error is an emergency, despite the fact that no one will die or even feel vaguely queezy because of it. No one would be happier than I if the damn things were swept off the face of the planet once and for all, but I am reluctantly forced to take up a position in their defence against the plethora of hogwash currently being spouted about their effect on health. Read the rest of this entry »
If It Walks Like a Duck…
August 11, 2011Remember Dr Jonathan V Wright of stomach acid fame? This should jog your memory:
When Theresa’s husband started leaving his socks in the fridge…
She was merely worried. But when he came back from a fishing trip minus the fish, his boat and his dog, they both decide to see Dr Wright. Vincent thought he was “losing it”, but it turned out he was actually missing the stomach acid he needed to break down his food. And without it, his brain cells weren’t being “fed” the nutrients they depend on. He’s sharp as a razor now!
Length of Life
July 13, 2011There is a Spanish company called Life Length that claims to be able to conduct a test that will tell you how long you have to live. It measures the lengths of your telomeres, which are the end caps on your chromosomes that get shorter each time the cell divides until they disappear and the cell can divide no more. By measuring the ratio of short telomeres to the average telomere length, Life Length claim to be able to estimate how much time you have left. I am unable to give you more detail of how they work their wonders because their web site is so incompetently built that clicking a link just returns you to the links page, but should you wish to avail yourself of their service you will have to part with the trifling sum of €550.
But why would you do that? The lengths of your telomeres cannot predict that you won’t die of heart disease, say, or economy class syndrome, or being hit on the head by a meteorite traveling at 12,000m/s, or even a bus moving at 20m/s. The main problem I have with this test is that it ignores all other factors that will play a part in determining when you are going to die. You can have telomeres the length of the great wall of China and it won’t deflect the executioner’s bullet, axe or needle one iota. So even after undergoing the tests you still won’t know what you wanted to find out. And why would you wish to find out? Will it make a huge difference to your life to know that you have a short or long time left to you? I would far prefer to be surprised when the grim reaper shows up.
Read the rest of this entry »
Holford’s Folly
June 21, 2011We have recently been bombarded with advertisements from a person called Patrick Holford who makes his nefarious living flogging unnecessary vitamin supplements to the gullible. It’s not surprising, therefore, that he defends the taking of vitamins in large doses for every conceivable ailment that could possibly afflict the human race, and if one happens to be healthy, then he advocates taking them anyway as a prophylactic measure. The problem with Mr Holford’s campaigns is that he is frequently economical with the truth to the point of comedy.

Here are some examples from a diatribe against the UK National Health Service (NHS), in which he criticises the NHS’s stance on vitamin supplementation. He claims that
The essential message is supplements don’t really work. They are probably dangerous and simply not worth the money. If you are sick what you need is drugs.
Which, needless to say, doesn’t suit Mr Holford’s interests. So he goes on the attack.
There has not been a single death from taking high dose vitamin supplements anywhere in the world. In the 35 years I’ve been in this field I haven’t encountered one serious adverse reaction to a vitamin, mineral or essential fat supplement.
Well, this is simply untrue. It is a lie, a porky pie, a whopper and a brazen fib. According to the 2004 Annual Report of the American Association of Poison Control Centers Toxic Exposure Surveillance System there were 62, 562 instances of vitamin overdose in the USA in 2004, 53 of which were life-threatening and 2 deaths actually occured. I remember doing an arctic survival course many years ago in which we were exhorted not to eat polar bear liver lest we fall victim to vitamin A toxicity, never mind the injuries that might accrue in obtaining the polar bear’s liver in the first place, particularly if it was still in use by the bear. Vitamins can be harmful. Holford goes on
If a supplement has an ‘active’ ingredient (meaning it works) it’s referred to the Medicines and Healthcare Regulatory Authority, and classified as a medicine, and banned for over the counter sale.
Well, exactly. The muck Holford flogs isn’t banned for sale over the counter. Draw your own conclusions.
But why is the NHS spending money persuading people not to take supplements?
Um, because they’re charged with protecting the nation’s health, perhaps?
I don’t know about you but I am getting pretty fed up with the money that’s being spent on propaganda to keep the pharmaceutical and medical industry in power while we, the public, get sicker and broker.
I wasn’t aware that the pharmaceutical and medical industries were “in power”, but I can quite understand why you don’t like the NHS’s stance on supplements. It makes Patrick Holford broker (well, slightly less stinking rich).
Holford was also responsible for advocating mega doses of vitamin C as a treatment for HIV infection instead of AZT. This should give you some idea of the extent of either his crackpothood or, depending on how generous you are feeling, his voracious appetite for profit.
Since he isn’t a doctor, I can’t call Holford a quack, but if he were he would be. Don’t waste your money on this flake’s rubbish.

Grumpy Old Man by Mark Widdicombe is licensed under a Creative Commons Attribution-Noncommercial-No Derivative Works 2.5 License
Predictions for 2011
December 29, 2010
This is the time of year when psychics and other riff-raff of the mystical realms emerge from their malodorous lairs to make known their predictions of events for the coming year. I am not a psychic, but I am the proud owner of a second-hand crystal ball, into which I shall now gaze for your benefit.
Tombstones
My crystal ball reveals that the following people will shuffle off this mortal coil during 2011.
Aretha Franklin (1942-2011): Her silver voice stilled at last, although still available on CD. Our loss is the gain of the choir invisible.
Stephen Hawking (1942-2011): English physicist. He will finally succumb to motor neuron disease, but his radiation will go on.
Barry Ronge (?-2011): Movie critic. No more shall his fatuous features fill our telescreens, or his unctuous tones drip like rancid cooking oil from our radio loudspeakers, or his silly scribblings take up our newspaper columns. Yay.
Natural Disasters
There will be a powerful earthquake on the Pacific rim this year which will leave thousands homeless.
The year will begin and end with severe blizzards in the Northern hemisphere.
Hurricanes will ravage the Caribbean, Gulf of Mexico and the East coast of the USA in the third quarter of 2011.
My crystal ball is silent on the subject of meteor strikes or volcanic eruptions, so I presume there will be none.
Sport
New Zealand will break their world cup jinx and carry home the 2011 Rugby World Cup.
South Africa will regain the number one ranking in test cricket.
Western Province will win the Curry Cup for 2011.
Politics
I can’t seem to get anything in focus. It’s all just a blur of interchangeable figures talking incomprehensible gibberish. Therefore just more of what we had this year.
Miscellaneous
The following numbers will be drawn in the lottery during the course of the year: 3 5 8 13 21 34
We shall revisit these predictions at the end of next year to see how they stand up compared to those of the “real” psychics.
Chill out and have fun in the new year.

Grumpy Old Man by Mark Widdicombe is licensed under a Creative Commons Attribution-Noncommercial-No Derivative Works 2.5 License
Quack Link
March 1, 2010“No more stress-headaches, insomnia, hangovers or mood swings.” So read the headline of one of the latest pieces of spam to hit my inbox. Well, spammer, I’m interested. I suffer from chronic insomnia and the occasional hangover . What could this miracle drug be? I read on.

Oh. It’s not a drug at all. It’s a little McGufty you hang around your neck like a piece of jewelery. How is this supposed to relieve my hangover? Well, according to the marketers of the Q-link pendant (which is what this spam is flogging), my hangovers are caused by “…being blasted with radiation from work monitors, cell phones and giant electricity pylons, we’re being zapped at home by televisions, mp3 players and game consoles.” And all this time I’ve thought hangovers were caused by drinking too much. Silly me.
So how does it work? It is alleged to contain a “resonating cell, (nature’s microchip)” which neutralizes all these pernicious “rays” we are constantly bombarded by. Oh wait, this is wonderful! I can “go on using my cellphone, watching TV and working on my computer”. I’m so relieved.
And it must really work because Tiger Woods wears one. Perhaps it should come with a warning: Do not drive or operate heavy machinery whilst wearing this thing. But they still haven’t really explained how it’s supposed to work.
OK, we’ve got there. Here comes the science:
Tuning YOUR body to the perfect frequency
It works like this. The Q-Link contains a resonating cell (also known as ‘nature’s microchip’) which works to counteract the effects the tools of modern life have on your body.
Put simply, it ensures your body is operating at its perfect frequency – a bit like the human equivalent of a tuning fork.
Your body is made up of trillions of cells. Now, each and every one of these cells has a frequency. Unfortunately every time your body experiences any stress, all these frequencies go out of synch…
This is where we come in. Q-Link’s proprietary technology ensures that all these frequencies are resonating harmonically.
Wow. Just wow. I’m overawed, flabbergasted at the scholarly erudition of this. How can I argue against what you say when you haven’t actually said anything?
But all this is quibbling. Priced at a mere R1,599 I’d have to be mad not to try it. Who knows, perhaps I’d be able to drink as much as I liked without suffering the morning after consequences. I wonder how much that would cost.

Grumpy Old Man by Mark Widdicombe is licensed under a Creative Commons Attribution-Noncommercial-No Derivative Works 2.5 License.
Nano Nonsense
October 9, 2009Every day I receive in my inbox a financial newsletter which tells me what’s going to happen in global markets and where I should most profitably be investing my non-existent wealth. Usually I read it avidly, dreaming of yachts and private jets, and skip impatiently past the blue advertising links embedded at various points in the text. But yesterday was a slow day, and I clicked on a link because it contained the phrase “nano-technology” and I love all things scientific and technological.
What a shock! It seems we are all about to be consumed by flesh-eating bacteria! Medicine is powerless! A worldwide conspiracy of government glitteratis has succeeded in keeping this secret from us, but now it is out. But do not despair! In a message that begins “Dear Germ-Conscious Friend” salvation is promised. It comes in the form of a device that appears to be no bigger than a cellphone and is catchily called the New Nano UV Disinfectant Light Scanner.
This amazing little device kills an incredible 99.99% of bacteria and viruses in ten seconds flat! Now I know that 93% of statistics are made up, but this surely looks as though it might be true? Any lingering doubts are dispelled when we are informed that this “proven, working technology” has been tested and given certification by independent laboratories.

A Happy Customer
I read avidly on, because I still haven’t got to the bit where the “nano” comes in. It seems a person called Eleanor Smith has purchased one of these doohickies and is delighted, her testimonial is above, unless it comes out below. Still haven’t got to the nano nitty-gritty yet, but here’s a relief: it’s 100% chemical free! I wonder what it could be made of? Here’s a picture (above or below) that constitutes absolute proof that this thing is on the up-and-up. I do wish they would put the “order” button at the top of the page—I could already have had one instead of still stupidly risking my life amongst all these horrible ravenous “E. Coli” and “C. Difficile”.
Proof Positive?
I get to the bottom, and still no explanation of the “nano”. Just this: “Now, using state of the art nano technology and multi-wavelengths including UVA-, UVB- and UVC-light…” Is it possible? No, surely they wouldn’t be so base as to use a scientific term to hoodwink, would they? That’s what “quantum” was invented for. If only they’d said: “in a revolutionary new application of quantum entanglement this device will provide 100% protection against being run over by buses or hit upside the head by falling meteorites” I would have smelled a rat immediately. Cunning rascals; we’d better have a sceptic take a closer look at their claims.
“By Jove, Holmes, look at this photograph! It’s obvious this thing has utterly destroyed these germ colonies.”
His lips stretched in a sardononic grin and his ice-blue eyes glittering, Holmes whipped out his magnifier and examined the photograph closely. “You notice, Watson, that the hand-written labels on the bottom row of Petri dishes labelled ‘before’ do not appear to match those on the top row, labelled ‘after’. The formation of the characters is quite different.”
“Gosh! You’re right, Holmes. So this light effects handwriting as well as killing germs! That is astonishing!”
“Would a better explanation not be that they are not the same Petri dishes?”
“But that would mean…” Watson tottered, his face ashen.
“Precisely, my dear Watson. These miscreants are using a new technique we detectives call ‘lying’. It consists of deliberately misrepresenting facts in order to cause their victims to believe things which are not true.”
“God, what can the world be coming to?”
Why not just take a photograph of a virgin petri dish, then grow bacteria in it, take another photograph then lie about which one was taken first? That’s the way I’d do it.
There is so much else wrong with this advert that it is hard to know where to start critisising it. There is the same ignorance of how to render biological names that I have complained about in another context; there is the typical scare tactic followed by the ‘white knight’ in his lab coat riding to the rescue; the appeal to authority (certificates and accreditation, for what? It doesn’t say, possibly for being safe to use in submarines); the use of scientific-sounding jargon which the ignorant lap up like ambrosia. And on and on.
Does this thing cause harm, though? Probably not, unless you shine it in your eyes for too long, or eat it, or poke it into bodily orifices. If the Eleanor Smiths of the world derive comfort from it and are prepared to part with R699.95…WHAT?! This thing probably doesn’t cost more than ten bucks to make. They’ve made me use an interrobang I’m so gobsmacked. Oh, wait, they give you a couple of free batteries as well. That’s OK, then.
Is it wrong to poke fun at or make money out of the idiots who infest this planet? After all, it’s not their fault they’re fools. Nope, if you can’t be bothered to think, you will get what you deserve, which is your money taken, and perhaps a dose of C. difficile as well, whatever that might be.

Grumpy Old Man by Mark Widdicombe is licensed under a Creative Commons Attribution-Noncommercial-No Derivative Works 2.5 License.
Posted by Mark Widdicombe 


